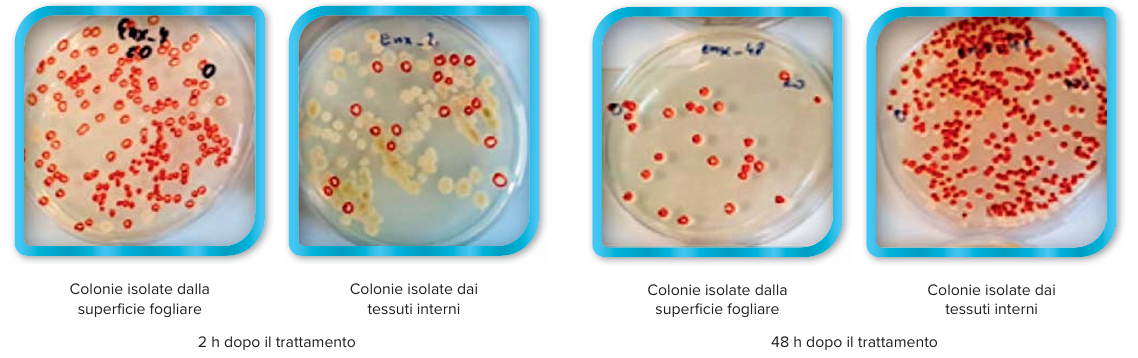

BACTIM®ENDOFIX


BACTIM® ENDOFIX è un bioprodotto microbico unico contenente batteri Pae nibacillus polymyxa in grado di colonizzare qualsiasi specie vegetale e fornire loro ulteriore azoto fissato direttamente dall’aria. I batteri rimangono attivi per tutta la stagione di crescita, dall’applicazione al raccolto, anche in condizioni di limitato assorbimento di azoto dal suolo. Ciò riduce il rischio di carenza di azoto durante il periodo di crescita, massimizza il potenziale di resa e migliora il vigore e la salute delle piante.
BACTIM® ENDOFIX fornisce alle piante azoto sotto forma di ioni ammonio (NH4+) facilmente assorbibili durante tutta la stagione di crescita.

Consentito in agricoltura biologica
BACTIM® ENDOFIX – composizione:

BACTIM® ENDOFIX – principali proprieta’:

BACTIM® ENDOFIX – modalita’ di impiego:
BACTIM® ENDOFIX e’ raccomandato per l’uso in tutte le colture agricole, frutticole e orticole, per via fogliare. L’ap
plicazione deve iniziare all’inizio della stagione vegetativa. Il prodotto può essere utilizzato in combinazione con
fertilizzanti fogliari e la maggior parte degli agrofarmaci.

BACTIM® ENDOFIX – efficacia confermata dalla ricerca:
BACTIM® ENDOFIX assicura che i batteri migrino e colonizzino rapidamente i tessuti vegetali, en tro due ore dall’applicazione.
Piastre di Petri con colonie di batteri Paenibacillus polymyxa, isolati dalla superficie fogliare e dai tessuti interni del mais, 2 ore e 48 ore dopo l’applicazione di BACTIM® ENDOFIX.
BACTIM® ENDOFIX stabilizza i livelli di azoto durante tutta la stagione di crescita.

BACTIM® ENDOFIX aumenta il contenuto di azoto delle piante, migliorandone il vigore, aumen tandone la resa.
Effetto dell’applicazione di BACTIM® ENDOFIX sulla produzione di frumento invernale.
Azienda agricola sperimentale, Polonia.

Effetto di BACTIM® ENDOFIX sullo sviluppo e il vigore del frumento invernale.
Azienda agricola sperimentale, Polonia.
